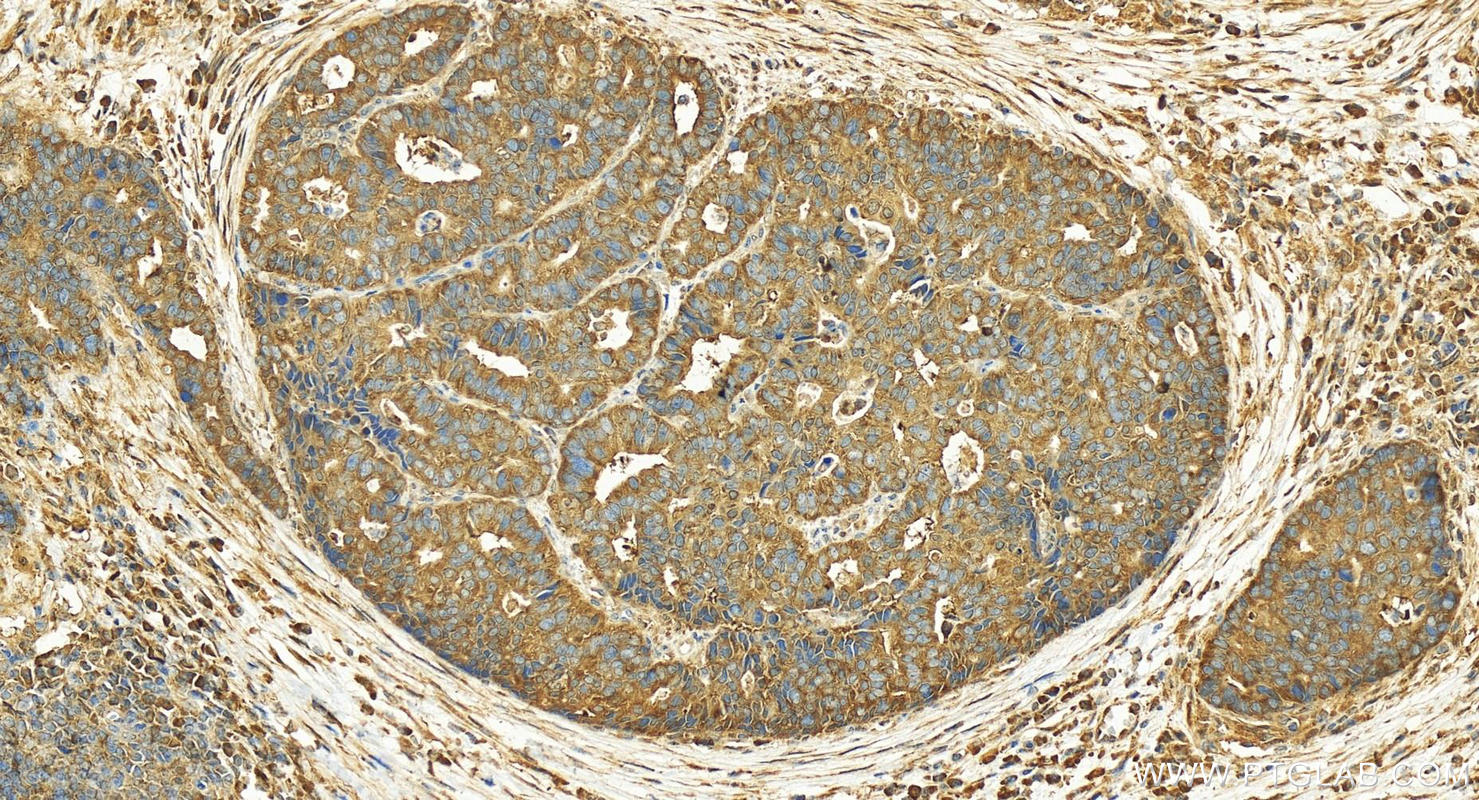

验证数据展示
经过测试的应用
| Positive WB detected in | HeLa cells, HepG2 cells, HL-60 cells, Jurkat cells, SGC-7901 cells |
| Positive IP detected in | HeLa cells |
| Positive IHC detected in | human lung cancer tissue, human gliomas tissue, human skin cancer tissue, human stomach cancer tissue Note: suggested antigen retrieval with TE buffer pH 9.0; (*) Alternatively, antigen retrieval may be performed with citrate buffer pH 6.0 |
| Positive FC (Intra) detected in | A375 cells |
推荐稀释比
| 应用 | 推荐稀释比 |
|---|---|
| Western Blot (WB) | WB : 1:500-1:1000 |
| Immunoprecipitation (IP) | IP : 0.5-4.0 ug for 1.0-3.0 mg of total protein lysate |
| Immunohistochemistry (IHC) | IHC : 1:50-1:500 |
| Flow Cytometry (FC) (INTRA) | FC (INTRA) : 0.50 ug per 10^6 cells in a 100 µl suspension |
| It is recommended that this reagent should be titrated in each testing system to obtain optimal results. | |
| Sample-dependent, Check data in validation data gallery. | |
产品信息
19497-1-AP targets FUT4 in WB, IHC, IF, FC (Intra), IP, ELISA applications and shows reactivity with human samples.
| 经测试应用 | WB, IHC, FC (Intra), IP, ELISA Application Description |
| 文献引用应用 | WB, IHC, IF |
| 经测试反应性 | human |
| 文献引用反应性 | human, mouse |
| 免疫原 |
Peptide 种属同源性预测 |
| 宿主/亚型 | Rabbit / IgG |
| 抗体类别 | Polyclonal |
| 产品类型 | Antibody |
| 全称 | fucosyltransferase 4 (alpha (1,3) fucosyltransferase, myeloid-specific) |
| 别名 | 4-galactosyl-N-acetylglucosaminide 3-alpha-L-fucosyltransferase, Alpha-(1,3)-fucosyltransferase 4, EC:2.4.1.152, ELAM-1 ligand fucosyltransferase, ELFT |
| 计算分子量 | 59 kDa |
| 观测分子量 | 95-140 kDa |
| GenBank蛋白编号 | NM_002033 |
| 基因名称 | FUT4 |
| Gene ID (NCBI) | 2526 |
| RRID | AB_10733222 |
| 偶联类型 | Unconjugated |
| 形式 | Liquid |
| 纯化方式 | Antigen affinity purification |
| UNIPROT ID | P22083 |
| 储存缓冲液 | PBS with 0.02% sodium azide and 50% glycerol, pH 7.3. |
| 储存条件 | Store at -20°C. Stable for one year after shipment. Aliquoting is unnecessary for -20oC storage. |
背景介绍
FUT4, also named as ELFT and FCT3A, belongs to the glycosyltransferase 10 family. FUT4 may catalyze alpha-1,3 glycosidic linkages involved in the expression of Lewis X/SSEA-1 and VIM-2 antigens. The expression of CD15 (acts as a terminal glycotope in glycoproteins and glycolipids) is directed by FUT4 in promyelocytes and monocytes. FUT4 is an antigenic epitope defined as a Lewis X carbohydrate structure is expressed on murine embryonal carcinoma cells (EC), murine ES and iPS cells, and murine and human germ cells. It is widely used as a positive surface marker for mouse undifferentiated ES and iPS cells and a negative surface marker for human undifferentiated ES and iPS cells. Expression is down-regulated following differentiation of murine EC and ES cells, while the differentiation of human EC and ES cells is accompanied by an increase in FUT4 expression. FUT4 is associated with cell adhesion, migration and differentiation. 19497-1-AP antibody detects the glycosylated isoform proteins around 95-140 kDa in SDS-PAGE. (PMID: 28706275, 28914881, 11278338)
实验方案
| Product Specific Protocols | |
|---|---|
| FC protocol for FUT4 antibody 19497-1-AP | Download protocol |
| IHC protocol for FUT4 antibody 19497-1-AP | Download protocol |
| IP protocol for FUT4 antibody 19497-1-AP | Download protocol |
| WB protocol for FUT4 antibody 19497-1-AP | Download protocol |
| Standard Protocols | |
|---|---|
| Click here to view our Standard Protocols |
发表文章
| Species | Application | Title |
|---|---|---|
ACS Appl Mater Interfaces Directing Induced Pluripotent Stem Cell Derived Neural Stem Cell Fate with a Three-Dimensional Biomimetic Hydrogel for Spinal Cord Injury Repair. | ||
Cell Death Dis α1,3-fucosylation of MEST promotes invasion potential of cytotrophoblast cells by activating translation initiation | ||
Cell Death Differ MicroRNA-200c impairs uterine receptivity formation by targeting FUT4 and α1,3-fucosylation.
| ||
Oncotarget Ginsenoside Rg3 inhibits epithelial-mesenchymal transition (EMT) and invasion of lung cancer by down-regulating FUT4.
| ||
Cell Death Dis Role of fucosyltransferase IV in epithelial-mesenchymal transition in breast cancer cells.
| ||
Front Mol Neurosci Transcriptional Repression of p53 by PAX3 Contributes to Gliomagenesis and Differentiation of Glioma Stem Cells. |